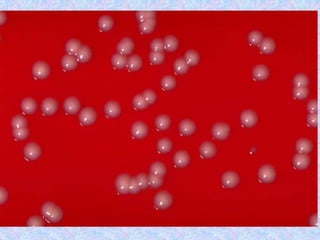

This document provides information about immunization and vaccine-preventable diseases. It discusses:
1. Immunization is a process that uses vaccines to stimulate immunity against infectious diseases. It has proven effective at controlling and eliminating diseases like smallpox.
2. Major vaccine-preventable diseases that kill children include measles, polio, pertussis, Hib, and pneumococcal diseases. Immunization is one of the most cost-effective health interventions.
3. The document then provides details on specific diseases like pertussis, its symptoms, complications, and treatment with antibiotics or immunization. It emphasizes the importance of clinical diagnosis and avoiding severe outcomes in infants.